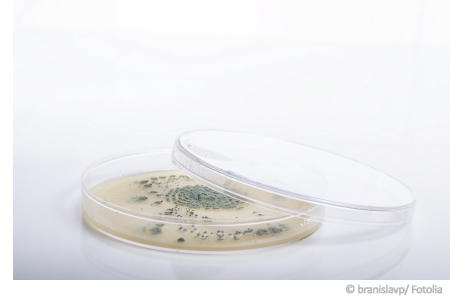

Schimmelpilzanalyse
Durch eine Schimmelpilzanalyse erfahren Sie, welche Schimmelpilzgattung für einen Befall in Ihrer Wohnung verantwortlich ist, oder ob eine relevante Belastung der Raumluft durch Schimmelpilzsporen vorliegt.
Die Schimmelpilzanalyse des Schimmelpilz Fachzentrums ist dabei einfach und schnell durchgeführt, und die klare Auswertung wird im Labor von erfahrenen Fachkräften übenommen. Außerdem freuen wir uns, Ihnen einen günstigen Preis für die Schimmelpilzanalyse anbieten zu können.
Dem Schimmel auf die Spur kommen- mit den Fachkräften des Schimmelpilz Fachzentrums!
Schimmelpilz Test Raumluft
Durch den Schimmelpilz Test Raumluft lassen sich Aussagen über die Konzentration von Schimmelpilzsporen in der Raumluft treffen. Sie erhalten außerdem Klahrheit, welche Schimmelpilzgattung für den Befall verantwortlich ist und bekommen den Ergebnisbericht mit einer grafischen Auswertung des Schimmelpilz Tests.
» Mehr Details zum Schimmelpilz Test Raumluft, bitte klicken!
Klicken Sie auf dieses Video und sehen Sie, wie einfach und schnell der Schimmel Test Raumluft (Passiv) funktioniert!
Schimmelpilz Test Abklatsch
Durch den Schimmelpilz Test Abklatsch lassen sich Aussagen über einen Schimmelpilzbefall an einer konkreten Stelle treffen (z.B. verdächtige oder befallene Wand). Außerdem erhalten Sie Klahrheit, welche Schimmelpilzgattung für den Befall ursächlich ist. Erläuterungen zur gefundenen Gattungen runden das Ergebnis ab).
» Mehr Details zum Schimmelpilz Test Abklatsch, bitte klicken!
Klicken Sie auf dieses Video und sehen Sie, wie einfach und schnell der Schimmel Test Abklatsch funktioniert!
Unser Leistungsumfang:

Und so einfach funktioniert eine Schimmelpilzanalyse:
➥ Alles was Sie zur Durchführung benötigen, finden Sie in unseren Schimmelpilz Test-Kit.
➥ Halten Sie sich dabei an die leicht verständliche, beigefügte Anleitung.
➥ Senden Sie die Schimmelpilzprobe und den ausgefüllten Erfassungsbogen an unser Labor.
➥ Bereits nach ungefähr zwei Wochen erhalten Sie ein ausführliches Ergebnis.
Schimmelpilzanalyse Infos
Die Giftwirkung, die von einem Schimmelbefall ausgeht, wird von vielen Menschen unterschätzt. Die Gifte, die Schimmel absondert, können sowohl akute als auch chronische Erkrankungen und Beschwerden auslösen. Besonders die Gesundheit von Kleinkindern, immunschwachen Menschen sowie Personen, die zu Allergien neigen, kann durch Schimmelsporen beeinträchtigt werden. Es gibt giftige und weniger giftige Schimmelpilze. Mit unserem speziell zusammengestellten Set zur Schimmelpilzanalyse können unsere Fachexperten im Labor eine Identifizierung der Schimmelpilzgattungen vornehmen.
Oftmals ist ein Schimmelbefall nicht von Anfang an deutlich sichtbar. Ein Indikator kann zum Beispiel ein muffiger Geruch im Raum sein. Schon zu diesem Zeitpunkt werden Sporen und Gifte eingeatmet, denn die Sporen sind so klein, dass sie mit bloßem Auge nicht erkennbar sind. Mit einer Schimmelpilzanalyse kann ein Schimmelproblem auch ohne sichtbaren Befall aufgedeckt werden. Mit einer einfachen Schimmelpilzanalyse können Sie aktiv etwas zu Ihrer Gesundheit und einer guten Raumluftqualität beitragen. In Anbetracht der Aufenthaltsdauer im eigenen Wohnraum raten Experten dringend zur Schimmelpilzanalyse sowie zu weiteren Vorsorgemaßnahmen insbesondere im Verdachtsfall.
✔️ Bis zu 6 Räume
✔️ Original airself
✔️ Schimmelpilzgattungen
✔️ Belastungseinschätzung
✔️ Schimmelpilzgattungen
✔️ Für verdächtige Stellen